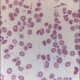
¿Qué es el síndrome de Zieve?

Para comprender por qué los niveles de bilirrubina total sérica pueden variar en diferentes etapas de la enfermedad hepática, es necesario entender cómo se produce y se elimina la bilirrubina en el organismo.
La bilirrubina es un producto de desecho que se forma cuando el hígado procesa la hemoglobina, una proteína que transporta el oxígeno en los glóbulos rojos. La hemoglobina se descompone en bilirrubina en el bazo y la médula ósea, y luego la bilirrubina se transporta al hígado a través del sistema circulatorio.
En el hígado, la bilirrubina se convierte en una forma soluble en agua llamada bilirrubina directa o conjugada. Esta bilirrubina conjugada es secretada en la bilis, que se almacena en la vesícula biliar y luego se libera al intestino delgado para ayudar en la digestión de las grasas.
En el intestino, la bilirrubina conjugada se transforma en urobilinógeno, que se excreta en las heces en gran parte, y una pequeña cantidad es reabsorbida en el torrente sanguíneo y llevada de nuevo al hígado, donde es capturada y eliminada en la bilis nuevamente (ciclo enterohepático).
Cuando existe algún problema en este proceso de metabolismo y eliminación de la bilirrubina, los niveles en sangre pueden aumentar, lo que lleva a la ictericia, que es una coloración amarillenta de la piel y los ojos.
En las etapas tempranas de la enfermedad hepática, los niveles de bilirrubina total sérica pueden ser normales o ligeramente elevados. Esto se debe a que el hígado aún puede realizar parcialmente su función de metabolizar y eliminar la bilirrubina, a pesar de la existencia de daño hepático.
En esta etapa inicial, la bilirrubina directa a menudo se encuentra ligeramente alta, lo que indica una alteración temprana en el proceso de excreción biliar de la bilirrubina. Es típico que esta anomalía evolucione a medida que la enfermedad hepática avanza y el daño en el hígado se agrava.
A medida que la enfermedad hepática progresa y el daño en el hígado se vuelve más significativo, la capacidad del hígado para procesar y eliminar la bilirrubina se ve cada vez más comprometida. Esto puede llevar a un aumento más marcado en los niveles de bilirrubina total sérica y a una mayor elevación de la bilirrubina directa.
En las etapas avanzadas de la enfermedad hepática, la ictericia puede volverse más evidente, y los pacientes pueden experimentar una coloración amarillenta más pronunciada en la piel y los ojos, junto con otros síntomas de enfermedad hepática grave.
Es importante tener en cuenta que la variación de los niveles de bilirrubina en diferentes etapas de la enfermedad hepática es solo una parte del cuadro clínico completo, y se deben evaluar otros marcadores hepáticos y los síntomas del paciente para realizar un diagnóstico preciso y determinar el estado de la enfermedad hepática. La monitorización regular y el seguimiento médico son fundamentales para abordar de manera adecuada la enfermedad hepática en todas sus etapas.

Síguenos en X: @el_homomedicus y @enarm_intensivo Síguenos en instagram: homomedicus y en Treads.net como: Homomedicus